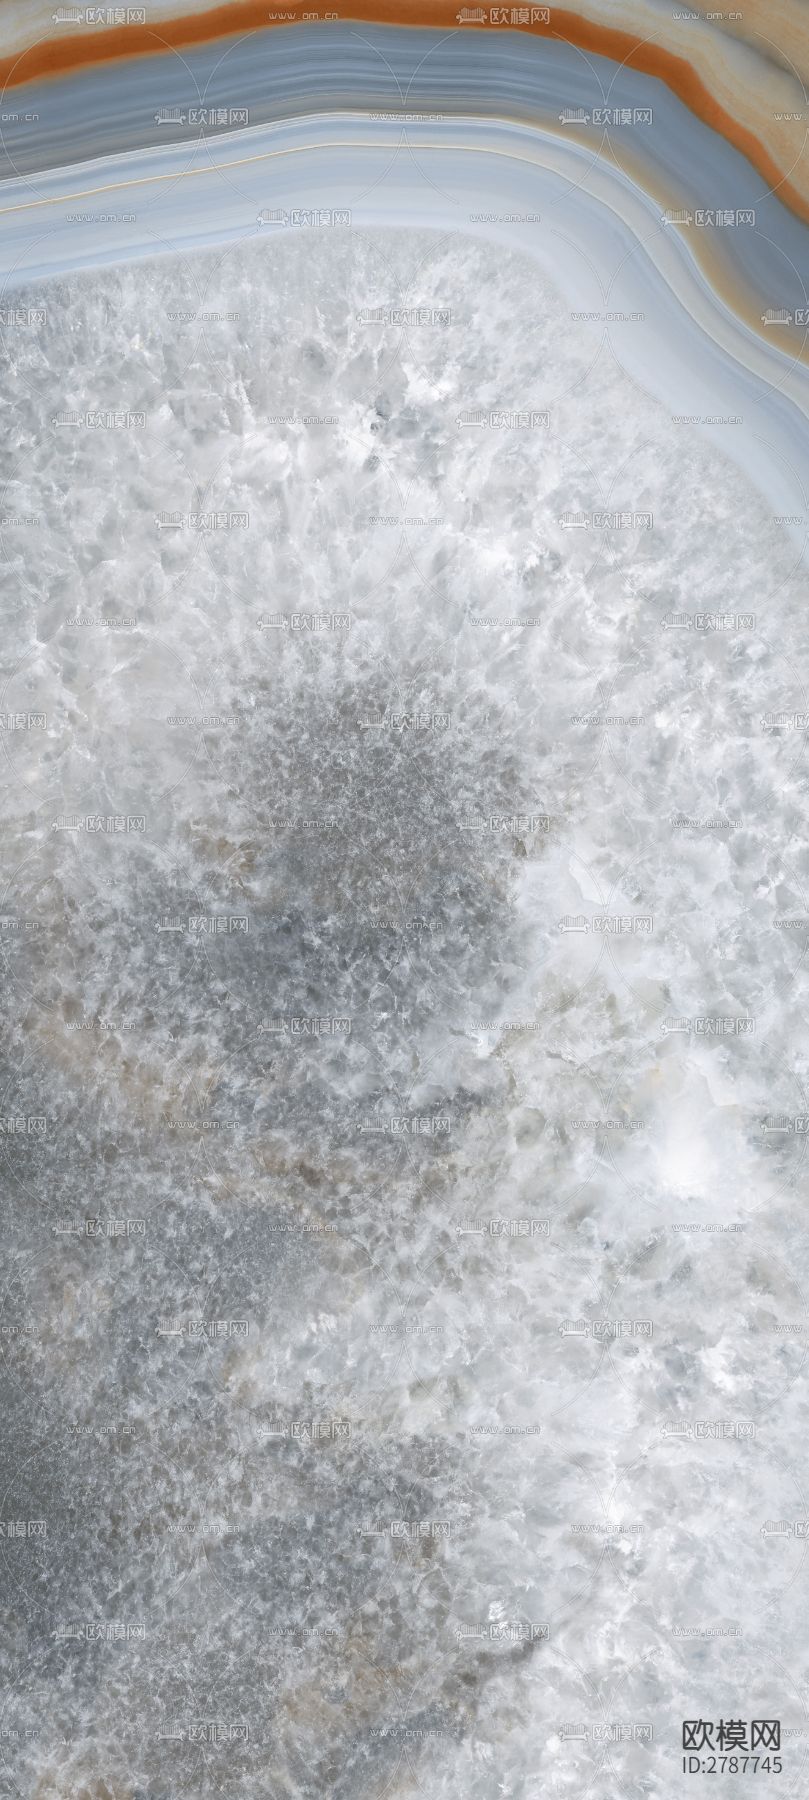
大理石 岩板 瓷砖下载（渲染图3）

{{ swiper.currentSlide }}/{{ JSON.parse('["\/Uploads\/Boss\/2023-07-27\/XXpKu1udp650PjmtowhlWbKza.jpeg","\/Uploads\/Boss\/2023-07-27\/TtkFoiFLbKnvsgNAqawX2AtBh.jpeg","\/Uploads\/Boss\/2023-07-27\/qut2o5uBejjMVNTDMTsOyJ2fD.jpeg"]').length }}
Windows客户端

千万模型素材 | 素材本地管理 | 支持3D/SU一键拖拽 | 实现MAX软件内一键渲染

欧模网提供优质的3d贴图下载,本次3d贴图主题为大理石 岩板 瓷砖,所属分类为石材,大理石 岩板 瓷砖_3d贴图ID:2787745是由欧模网用户OM于2023年07月27日上传。
用户在本站下载的电子素材,著作权归欧模网及相关权利人所有。用户应按照欧模网的要求进行使用,不将其用于任何商业、促销、软文、代言、广告宣传或推销等目的,不向第三方提供或许可第三方使用;不得使用“欧模”、“欧模网”等本站注册商标。如发现有上述禁止行为,欧模网有权取消用户资格,扣除用户账户中的全部余额,要求用户立即停止使用电子素材并赔偿因此给欧模网造成的全部损失。
您所购买并下载的素材,系由发布人进行上传并出售,您认为该内容侵犯您合法权益的,请点击查看侵权申诉规则
 小O设计库
小O设计库
面向广大设计领域用户打造的一站式素材管理工具
{{ advantage.desc }}
我已安装小O设计库,点击立即使用